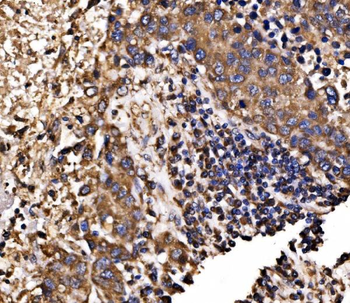
Calnexin/CANX Antibody

You have no items in your shopping cart.
- CALB1 Rabbit Polyclonal Antibody [orb182649]Featured

ICC, IF, IHC-Fr, IHC-P, WB
Human, Mouse, Rat
Bovine, Canine, Equine, Porcine, Rabbit
Rabbit
Polyclonal
Unconjugated
50 μl, 100 μl, 200 μl - Calbindin/CALB1 Antibody [orb443152]
ELISA, FC, IF, IHC, WB
Human, Mouse, Rat
Rabbit
Polyclonal
Unconjugated
100 μg - Calnexin/CANX Antibody [orb865367]
ELISA, FC, ICC, IF, IHC, WB
Human, Mouse
Rabbit
Polyclonal
Unconjugated
100 μg - mGluR1/GRM1 Antibody [orb654429]
ELISA, FC, IHC, WB
Human, Mouse, Rat
Rabbit
Polyclonal
Unconjugated
100 μg - GC Antibody [orb1410269]
IHC
Human
Mouse
Monoclonal
Unconjugated
20 μg, 100 μg, 100 μg (without BSA and Azide) - GC Antibody [orb1410270]
IHC
Human
Mouse
Monoclonal
Unconjugated
20 μg, 100 μg, 100 μg (without BSA and Azide) - CYP24A1 rabbit pAb Antibody [orb767830]Featured

ELISA, IF, IHC, WB
Human, Mouse, Rat
Polyclonal
Unconjugated
100 μl, 50 μl - CYP2R1 rabbit pAb Antibody [orb767556]Featured

ELISA, IF, IHC, WB
Human, Monkey, Mouse
Polyclonal
Unconjugated
50 μl, 100 μl - Calbindin 2 Antibody / CALB2 / Calretinin [orb639534]
IHC-P, WB
Human
Mouse
Monoclonal
Unconjugated
100 μg, 20 μg